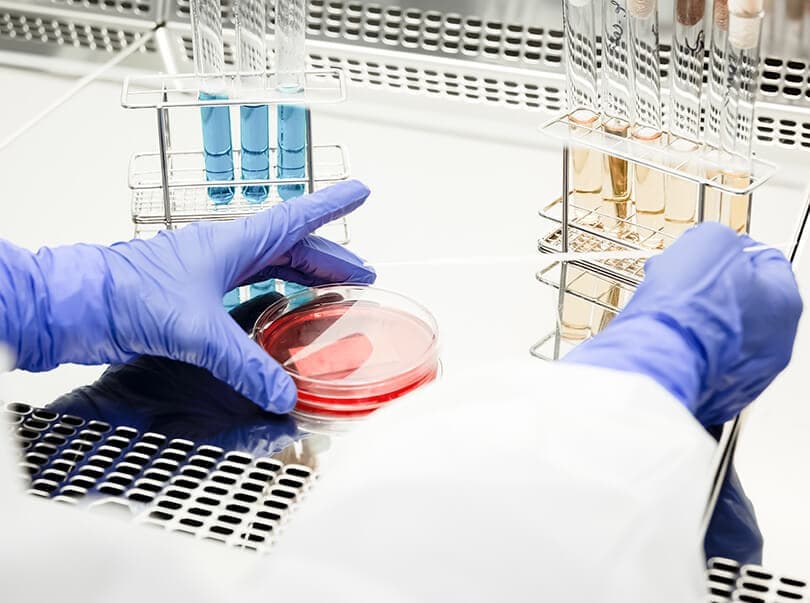

คุณมี “ภูมิคุ้มกันที่ลดลง”โดยที่คุณไม่รู้ตัวรึเปล่า?
เมื่อระบบภูมิคุ้มกันอ่อนแอ อาจทำให้ไข้หวัดธรรมดา ๆ ที่ปกติจะหายเร็ว มีอาการที่รุนแรงมากขึ้นได้ควรจะทราบไว้ว่า สภาพแบบนั้นเป็นสภาพที่อันตรายมาก
การรักษาด้วยภูมิคุ้มกันของคลินิกเรา มีจุดมุ่งหมายเพื่อเพิ่มความสามารถของเซลล์ภูมิคุ้มกันและทำให้ร่างกายเสี่ยงต่อโรคน้อยลง
กลไกของระบบภูมิคุ้มกัน
แนะนำสมาชิกของภูมิคุ้มกันโดยกำเนิด และภูมิคุ้มกันที่ได้มาภายหลัง
กลไกของระบบภูมิคุ้มกัน มี 2 กลไกหลัก ๆ คือ “ภูมิคุ้มกันโดยกำเนิด” และ “ภูมิคุ้มกันที่ได้มาภายหลัง”
“ภูมิคุ้มกันโดยกำเนิด” เป็นระบบการป้องกันตัวเองจากโรคที่เรามีตั้งแต่กำเนิด เป็นระบบที่สามารถจดจำและโจมตีเชื้อโรคและเซลล์ที่เป็นอันตรายได้อย่างรวดเร็ว
อาการหลัก
เซลล์เดนไดรต์
มีหน้าที่ส่งต่อข้อมูลของเชื้อโรค
ให้กับลิมโฟไซต์
แมคโครฟาจ
มีหน้าที่กำจัด
เชื้อโรคที่ตายแล้ว
แกรนูโลไซต์
(นิวโทรฟิล, อีโอซิโนฟิล, เบโซฟิล)
โจมตีเชื้อโรค
เซลล์เอ็นเค
มีหน้าที่ตรวจตราร่างกาย
และมีพลังโจมตีสูง
ต่อเชื่อโรค
ภูมิคุ้มกันที่ได้มาหลังการติดเชื้อหรือไวรัส ซึ่งเฉพาะเจาะจงต่อเชื้อเหล่านั้น จะถูกเรียกว่า “ภูมิคุ้มกันที่ได้มาภายหลัง” “ภูมิคุ้มกันที่ได้มาภายหลัง” นี้ ไม่ได้มีตั้งแต่กำเนิดเหมือน “ภูมิคุ้มกันโดยกำเนิด”
ตัวอย่างภูมิคุ้มกันประเภทนี้ คือภูมิคุ้มกันต่อโรคหัด และหัดเยอรมัน
ภูมิคุ้มกันที่ได้มาภายหลัง
เซลล์ทีเฮลเปอร์
มีหน้าที่ส่งต่อข้อมูลของเชื้อโรค
ให้กับลิมโฟไซต์
เซลล์ทีซับเพรสเซอร์
โจมตีเชื้อโรค
เซลล์ทีคิลเลอร์
แกรนูโลไซต์
ออกคำสั่งยับยั้ง
การโจมตีเชื้อโรค
เซลล์บี
โจมตีเชื้อโรค
ด้วยสิ่งที่เรียกว่า
แอนติบอดี้
ระบบนี้ทำให้ร่างกายเป็นโรคยาก เรียกกันโดยทั่วไปว่า “เกิดภูมิคุ้มกัน” นั่นเอง
ว่ากันว่าในร่างกายคนเรา มีเซลล์มะเร็งเกิดขึ้นใหม่โดยธรรมชาติวันละหลายพันเซลล์
ทำไมถึงเป็นมะเร็งได้ล่ะ?
เพราะว่า “เซลล์ยับยั้งภูมิคุ้มกัน” ที่ทำให้ภูมิคุ้มกันอ่อนแอลง จะเข้ามาล้อมเซลล์มะเร็งและทำหน้าที่เหมือนเป็นเกราะกำบังให้กับเซลล์มะเร็ง ป้องกันการโจมตีจากระบบภูมิคุ้มกัน หากเซลล์มะเร็งที่ได้รับการปกป้องจากเซลล์ยับยั้งภูมิคุ้มกันเพิ่มจำนวนต่อไปเรื่อย ๆ ก็จะเข้าสู่ระยะที่เป็นโรค “มะเร็ง” นั่นเอง
ความแตกต่างของพลังระบบภูมิคุ้มกัน
ความแตกต่างนี้คือ “ความแตกต่างของพลังระบบภูมิคุ้มกัน” นั่นเอง ถึงจะอยู่ในสภาพแวดล้อมที่หนาวเย็น และมีคนที่ติดเชื่อที่แพร่ง่ายอยู่ใกล้ ๆ คนที่มีพลังระบบภูมิคุ้มกันสูง ก็สามารถป้องกันตัวเองจากเชื้อภายนอกได้
ที่จริงแล้ว นักกีฬามีภูมิคุ้มกันอ่อนแอได้ง่าย
จริงอยู่ว่าการออกกำลังกายที่พอเหมาะจะช่วยเสริมภูมิคุ้มกัน แต่การออกกำลังกายที่หนักหน่วง กลับทำให้ภูมิคุ้มกันอ่อนแอลง มีผลการวิจัยว่าคนที่เล่นกีฬาที่หนัก เช่น มาราธอน จะมีโอกาสเป็นหวัด (ติดเชื้อที่ทางเดินหายใจส่วนบน) มากกว่าคนที่ไม่ออกกำลังกายประมาณ 2-6 เท่า
การรักษาด้วยเซลล์ภูมิคุ้มกัน เพื่อเสริมพลังภูมิคุ้มกัน
ส่งเสริมสุขภาพ ป้องกันมะเร็ง
มะเร็ง ป้องกันการเกิดซ้ำ
การรักษาด้วยภูมิคุ้มกันนี้ มีการวิจัยและทดลองรักษาในโรงพยาบาลมหาวิทยาลัยาแล้วสิบกว่าปี และมีการประยุกต์ใช้ทางคลินิกแล้วด้วยโรงพยาบาลมหาวิทยาลัยเช่นนี้มีอยู่หลายสิบแห่ง และเป็นวิธีการรักษาแบบใหม่ด้รับความสนใจอย่างมาก